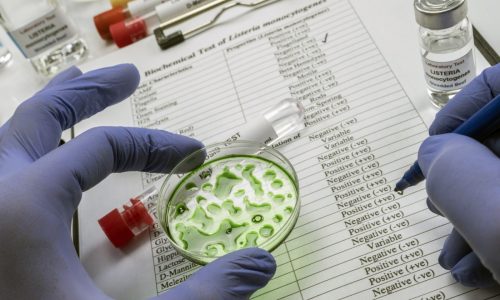
Listeria recall of chicken hits Publix, Target, Amazon, Kroger, Albertsons and others

Trump tested the limits on using the military at home. If elected again, he plans to go further
By STEPHEN GROVES WASHINGTON (AP) — During his first term as president, Donald Trump tested the limits of how he could use the military to...
Trump tested the limits on using the military at home. If elected again, he plans to go further
By STEPHEN GROVES WASHINGTON (AP) — During his first term as president, Donald Trump tested the limits of how he could use the military to...
Ramsey County municipal races: Arden Hills city council
Four candidates are running for two seats on the Arden Hill City Council in November’s election. General information about the Nov. 5 election is online...
Washington County races: District 3 Board of Commissioner candidates
Four candidates are running for the Washington County Board of Commissioners District 3 seat in November’s election. District 3 serves the cities of Afton, Bayport, Baytown Township, Lake Elmo, Lake...
Listeria recall of chicken hits Publix, Target, Amazon, Kroger, Albertsons and others
David J. Neal | (TNS) Miami Herald The listeria-launched recall of nearly 10 million pounds of meat and chicken products has reached the store brands...
OriginTrail Market Capitalization Tops $202.90 Million (TRAC)
OriginTrail (TRAC) traded up 3.7% against the US dollar during the twenty-four hour period ending at 13:00 PM Eastern on October 14th. One OriginTrail token...